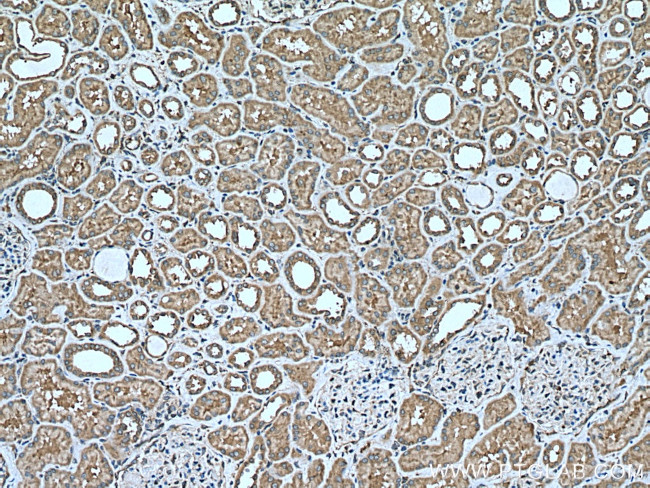
CCDC50 Antibody in Immunohistochemistry (Paraffin) (IHC (P))

Search
Proteintech
CCDC50 Polyclonal Antibody
{{$productOrderCtrl.translations['antibody.pdp.commerceCard.promotion.promotions']}}
{{$productOrderCtrl.translations['antibody.pdp.commerceCard.promotion.viewpromo']}}
{{$productOrderCtrl.translations['antibody.pdp.commerceCard.promotion.promocode']}}: {{promo.promoCode}} {{promo.promoTitle}} {{promo.promoDescription}}. {{$productOrderCtrl.translations['antibody.pdp.commerceCard.promotion.learnmore']}}
产品信息
21082-1-AP
种属反应
宿主/亚型
分类
类型
抗原
偶联物
形式
浓度
规格
纯化类型
保存液
内含物
保存条件
运输条件
产品详细信息
Immunogen sequence: MAEVSIDQS KLPGVKEVCR DFAVLEDHTL AHSLQEQEIE HHLASNVQRN RLVQHDLQVA KQLQEEDLKA QAQLQKRYKD LEQQDCEIAQ EIQEKLAIEA ERRRIQEKKD EDIARLLQEK ELQEEKKRKK HFPEFPATRA YADSYYYEDG GMKPRVMKEA VSTPSRMAHR DQEWYDAEIA RKLQEEELLA TQVDMRAAQV AQDEEIARLL MAEEKKAYKK AKEREKSSLD KRKQDPEWKP KTAKAANSKS KESDEPHHSK NERPARPPPP IMTDGEDADY THFTNQQSST RHFSKSESSH KGFHYKH (1-306 aa encoded by BC065004)
靶标信息
This protein is a bifunctional mRNA-capping enzyme exhibiting RNA 5'-triphosphatase activity in the N-terminal part and mRNA guanylyltransferase activity in the C-terminal part. Catalyzes the first two steps of cap formation: by removing the gamma-phosphate from the 5'-triphosphate end of nascent mRNA to yield a diphosphate end, and by transferring the gmp moiety of GTP to the 5'-diphosphate terminus.
仅用于科研。不用于诊断过程。未经明确授权不得转售。
篇参考文献 (0)
生物信息学
蛋白别名: Coiled-coil domain-containing protein 50; Protein Ymer; putative C3orf6 protein homolog; Ymer protein
基因别名: C3orf6; C3orf6h; CCDC50; DFNA44; YMER
UniProt ID: (Human) Q8IVM0, (Mouse) Q810U5, (Rat) Q810U0
Entrez Gene ID: (Human) 152137, (Mouse) 67501, (Rat) 288022